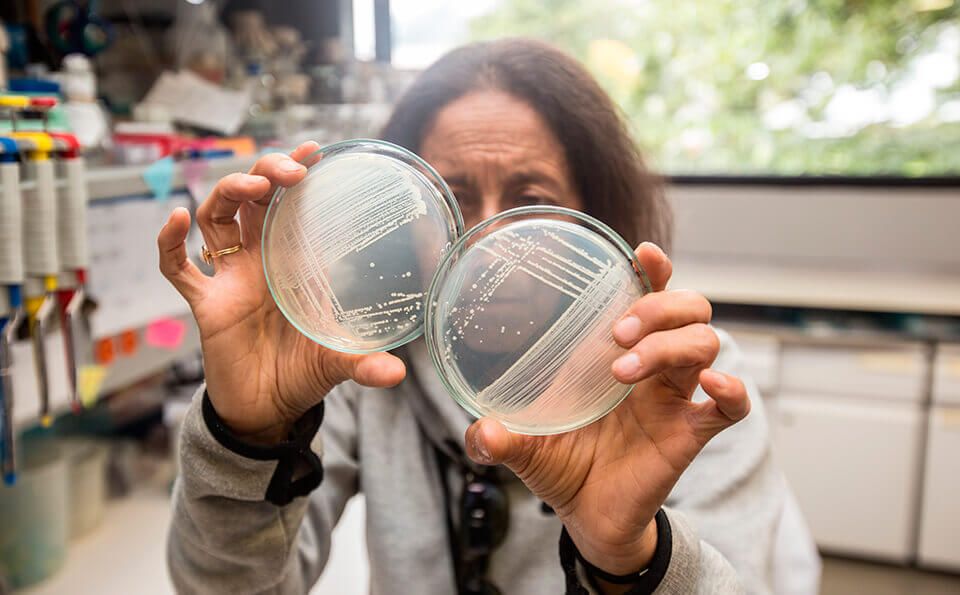

Nuestra Historia
Nuestra Historia
Elizabeth Grose Ph.D, Bióloga y Microbióloga fundadora del Departamento de Ciencias Biológicas de la Facultad de Ciencias de la Universidad de Los Andes, creó en el año 1979 el Centro de Investigaciones Microbiológicas-CIMIC, con base en su experiencia en las diferentes líneas de investigación en Microbiología desarrollada en la Universidad desde la década de los años 60.
La misión del CIMIC se concentró en el conocimiento, la conservación, el impacto y la aplicación de microorganismos pertenecientes a las bacterias y los hongos en diferentes ambientes.
La vinculación de estudiantes comenzó con Maria Szekessy y María Caridad de García, que cursaban los últimos semestres y para finalizar su grado en microbiología en la década de los 60, dirigidas por la Dra, Grose iniciaron los primeros muestreos para el aislamientos y posterior estudio de diversos hongos de interés en agricultura y salud con el fin de ir conformando la colección de hongos.

El CIMIC fue el primer laboratorio con un cepario especializado de bacterias y hongos (año 1993), y el laboratorio de referencia ante el Ministerio del Medio Ambiente y Ministerio de Salud para el monitoreo y evaluación de la calidad de consorcios microbianos para tratamientos ambientales (años 1995-2001) También fue el primer laboratorio registrado en el año 2002 para evaluar la calidad microbiana de los diferentes bioinsumos agrícolas importados y producidos en nuestro pais con base en estos trabajos, se generaron 20 normas técnicas registradas en el ICA-LAΝΙΑ. Después de la muerte de la dra. Elizabeth Grose en el año 1997, Jenny Dussan Ph.D paso a dirigir el CIMIC.

1993
En 1993 el grupo conformó la primera colección de microorganismos, bacterias/hongos aislados de diferentes habitats y de regiones del país, con potencial en diversas líneas de investigación y en el año 2001 se convirtió en la primera colección microbiana registrada en el Instituto Alexander Von Humboldt.
Por la solidez de la Colección de microorganismos conformada, el grupo fue invitado por el Laboratorio de Insumos Agrícolas-LANIA del Ministerio de Agricultura , por lo tanto, todo el grupo de investigación, estudiantes de pregrado, maestría y los profesores de este

1997
Las investigaciones financiadas por Colciencias en microbiología molecular y control biológico de mosquitos vectores de enfermedades tropicales (1992- 1996), asi como la financiación dada pouta compañía Occidental de Colombia para el desarrollo de tecnologias limpias en procesos de bioremediación de aguas residuales (1990-1996), y estudios moleculares de las bacterias implicadas en los diferentes tratamientos de biodegradación de compuestos contaminantes, marcaron el inicio del grupo MAB del CIMIC como grupo pionero en microbiologia ambiental en Colombia.
Con el apoyo del programa ALFA-Unión Europea, Harvard-Los Andes Fund, Colciencias, Banco de la República, multinacionales del sector petrolero, entre otros, el grupo MAB se ha constituido en líder de la evaluación de la biodiversidad de microorganismos en ambientes inhospitos con potencial para ser bioprospectadas en procesos de bioremediación y control de poblaciones bacterianas, que han permitido el desarrollo de consorcios biodegradadores exitosos, asi como cocteles de virus bacteriofagos para el control de bacterias causantes de infecciones (Pseudomonas aeruginosa, Salmonella sp Cutibacterium (antes Propionibacterium) acnes. Klebsiella sp. Escherichia coli, entre otros)
El grupo inició en el año 2007 sus investigaciones en virus bacteriófagos (fagos) y fagoterapia, en su línea de investigación en bioprospeccion microbiana Se han desarrollado trabajos con fagos contra cepas de P. aeruginosa resistentes a múltiples antibióticos cuyos resultados in vivo en ratones fueron sorprendentes. En colaboración con CENIACUA, se aislaron bacteriófagos contra bacterias patógenas de camarones y se evaluó el efecto de ellos. Individualmente y en cóctel, los resultados evidenciaron que el uso de un cóctel de tres fagos controló la aparición de resistencia bacteriana y la población de bacterias permaneció sensible a la acción de los fagos durante el tiempo evaluado.

En un proyecto cofinanciado por Colciencias, y en colaboración con el grupo COIPARS de Corpoica, se caracterizaron bacteriófagos liticos contra Salmonella sp., bacteria Gram negativa causante de salmonelosis. La eficiencia in vitro e in vivo de los fagos fue evaluada con la perspectiva de utilizarlos en la industria avícola. Del trabajo realizado derivó la solicitud de patente para el producto Salmofree®, la cual ya fue oforgada en Colombia y Estados Unidos. Además, también fue concedida una patente de formulación basada en fagos para el control de C. acnes en Colombia.
Como parte de la estrategia de transferencia del conocimierito, el grupo realiza actividades como el taller de seguimiento microbiológico de P. aeruginosa y otros microorganismos asociados a fibrosis quística en asocio con la organización Novartis y con la participación de profesionales de apoyo para el diagnóstico clínico de varias ciudades del país. También organizó y apoyo la realización del taller sobre microbiología para el Club de Maestros de Pequeños Cientificos, como contribución al conocimiento y aplicación del método científico entre profesores de educación primaria y secundaria. Además, organizó y ofreció la capacitación a funcionarios del INVIMA sobre validación de potencia de antibióticos, a solicitud de dicha institución. Se estableció una interacción directa con la empresa CORE S.A. para la capacitación de alto nivel (doctorado y maestría) de su personal en temas de biología de microorganismos y biorremediación. Recientemente, el grupo fue un miembro activo del proyecto COVIDA para la detección del virus causarite de la COVID-19 en población asintomática, a través de la creación de las brigadas de muestreo y capacitación en toma de muestras. Desde el año 2024, Martha Vives Ph.D, tomo la dirección del centro de investigación.
Grandes logros
1.
La conformación de la primera colección de microorganismos nativos del país como parte del Museo de Historia Natural UniAndes.
2.
Creación de las primeras normas de control de calidad de alimentos en el país.
3.
Primer laboratorio de referencia ante el Ministerio del Medio Ambiente y Ministerio de Salud para el monitoreo y evaluación de la calidad de consorcios microbianos para tratamientos ambientales
4.
Lideres en capacitación para el muestreo durante la pandemia de la covid 19 y rastreo del virus en población asintomática.
5.
Creación del primer emprendimiento de base científica basado en bacteriófagos en Colombia.
6.
Formulación de consorcios eficaces para la remoción de contaminantes ambientales.
Edificio J - Piso 2 - 3
Teléfono: (+57) 601 3 39 4999 Ext 2767 | 1461
Carrera 1 No.18A - 12
Bogotá, Colombia
